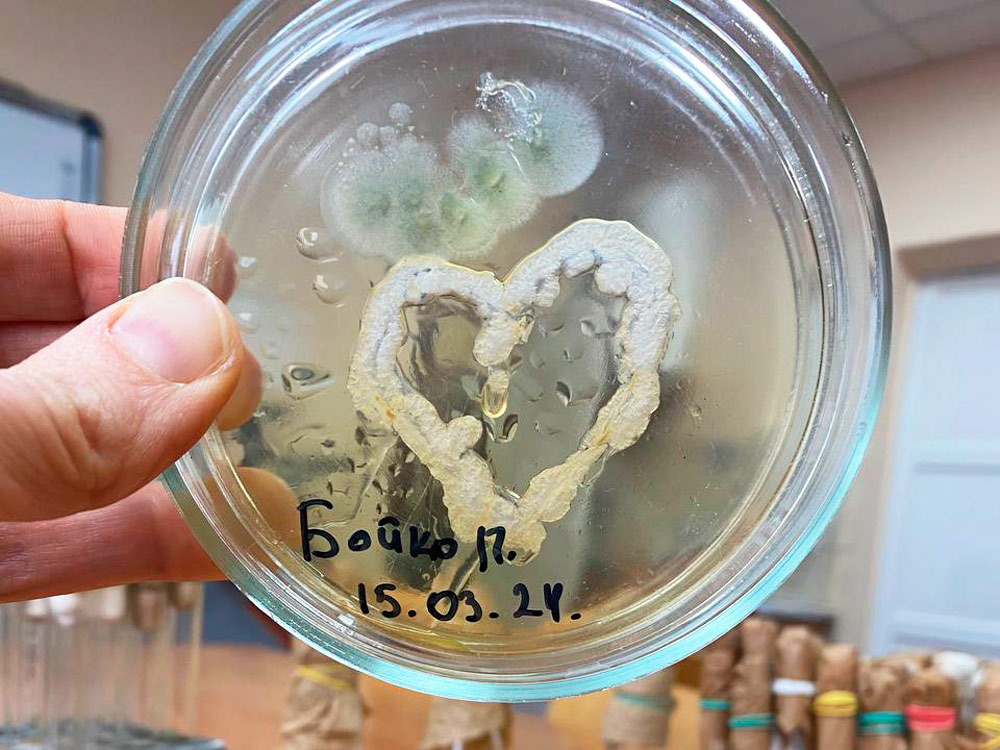

Аби діти могли свідомо вибрати сферу майбутньої діяльності та дізнатися якомога більше інформації про світ природничих наук, 26 березня 2024 року на кафедрі природничих наук та методик їхнього навчання відбулась профорієнтаційна зустріч із учнями КЗ «Ліцей «Максимум» Кропивницької міської ради». Захід був організований за підтримки вчителя біологїі та хімії закладу освіти Євгенія Зосімова та студентки групи ХБ23М Тетяни Затуливітер.
Детальніше...
На кафедрі природничих наук і методик їхнього навчання відбулися чергові засідання наукового гуртка «Біохімії та фізіології».
Україна – це наш спільний дім!
Щороку 8 квітня відзначається Міжнародний день ромів.
У цей день, 1971 року, в рамках першого Всесвітнього ромського конгресу було офіційно започатковано ромський громадський рух. Тоді ж було затверджено національний прапор і гімн ромського народу – найбільшої етнічної меншини в Європі.
30 березня студенти другого (магістерського) рівня вищої освіти спеціальності “Середня освіта (Географія)” та викладачі-географи відвідали відкриту лекцію з теми «Геополітична структура світу. Геополітичні конфлікти», яку провів кандидат географічних наук, доцент, доцент кафедри соціально-економічної географії і регіонознавства імені Костянтина Нємця факультету геології, географії, рекреації і туризму Харківського національного університету імені Василя Каразіна Юрій Іванович Кандиба. Лекція проведена в рамках проєкту “Геоздибанка”, організованого Українською спілкою молодих географів.
01 квітня 2024 року на кафедрі природничих наук і методик їхнього навчання відбулася звітна онлайн конференція, де студенти спеціальностей 014 Середня освіта (Біологія та здоров’я людини) та 014 Середня освіта (Хімія) денної та заочної форм навчання підбили підсумки та поділилися враженнями й власними напрацюваннями та здобутками під час практики.